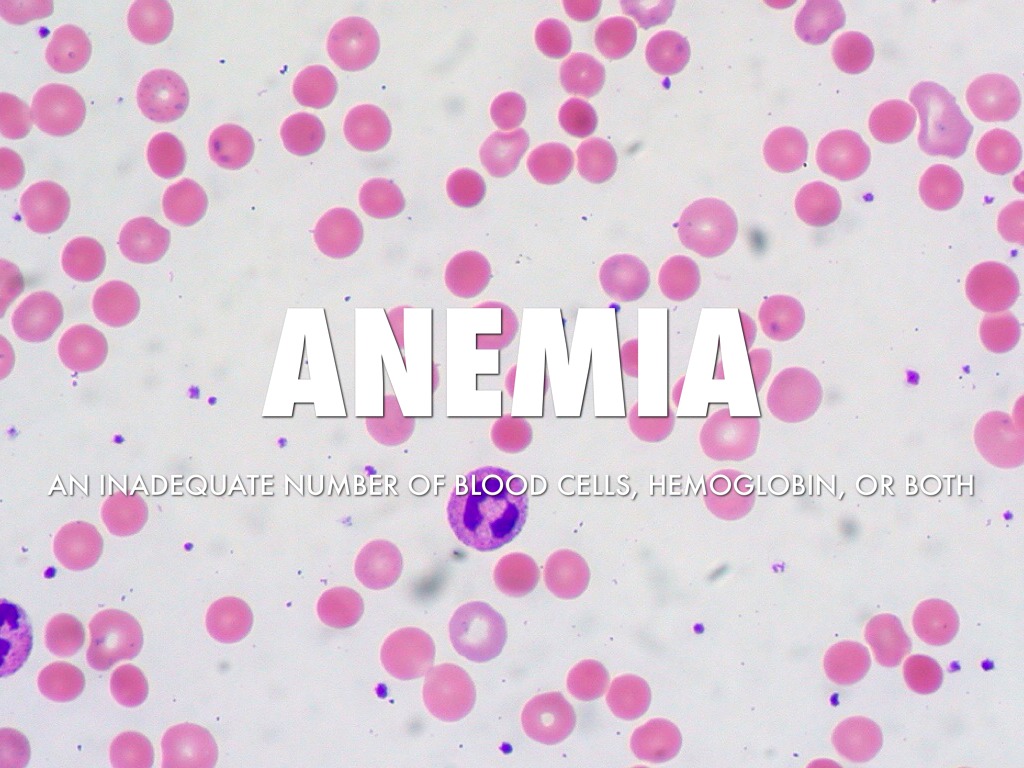
Anemia

You’ve Reached Your Account Limit!
Your Haiku Deck plan includes one Haiku Deck. Please upgrade to one of our paid plans in order to create or edit additional decks. You’ll love the additional features Haiku Deck subscribers get and you’ll be helping to support Haiku Deck’s mission — to make it 10 times faster and easier for you to create presentations that are 10 times better.
Travel and Lifestyle Presentation Templates
Presentations created 19 March 2014
Should Schools Teach Cursive
byDavid Fedchuk
|341 views
Art and Design, Business, Education, Events, How To, Humor, Inspiration, Science and Technology, Travel and Lifestyle

Dates are GMT







 Get Haiku Deck Pro
Get Haiku Deck Pro Saving your changes...
Saving your changes...